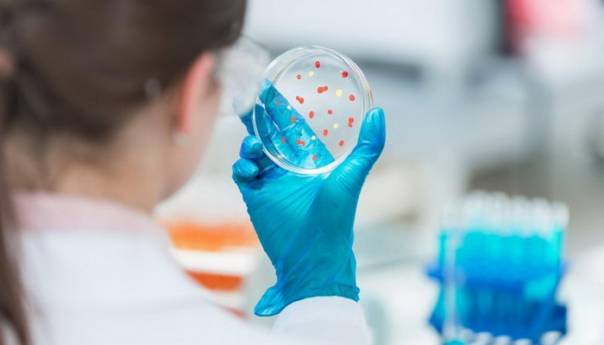
Ruski lijek protiv koronavirusa će biti registrovan ove godine

On je za agenciju Russia Today rekao da će se efikasnost lijeka proučavati tokom druge faze ispitivanja.
Haitov, koji je član Ruske akademije nauka, istaknuo je da je danas teško reći kada će biti gotovo ispitivanje.
"Uložit ćemo sav trud da što prije počnemo drugu fazu, a za to postoje svi preduslovi, jer se lijek pokazao vrlo efikasnim tokom faze prije kliničkog ispitivanja. Registrovat ćemo lijek čim druga faza bude gotova, nadam se ove godine", naglasio je Haitov.
Prema riječima Haitova, rezultati testiranja biće objavljeni kako u Rusiji tako i u inostranstvu, uz napomenu da se već radi na njihovom objavljivanju, prenio je TASS.
Direktor Agencije Veronika Skvorcova izjavila je ranije da je lijek "mir-19" zasnovan na mikro ribonukleinskoj kiselini (RNK) koja blokira određene dijelove virusne RNK.
Ona je najavila da bi prva faza kliničkog testiranja trebalo da bude završena do polovine marta.
(Vijesti.ba)
Chat čitatelja